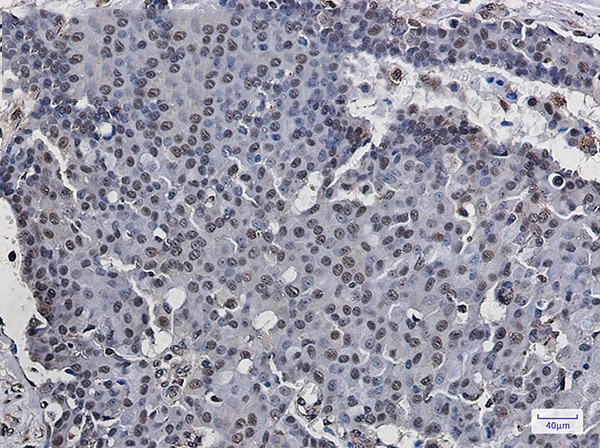
产品细节图片2

相关产品推荐更多 >
万千商家帮你免费找货
0 人在求购买到急需产品
- 详细信息
- 文献和实验
- 技术资料
- 免疫原:
A synthetic peptide of human POLR2E
- 形态:
liquid
- 保存条件:
Store at -20˚C
- 克隆性:
Monoclonal antibody
- 适应物种:
Human;Mouse;Rat
- 保质期:
12 months
- 抗原来源:
Recombinant Rabbit
- 供应商:
南京赛戈巍生物科技有限公司
- 宿主:
Recombinant Rabbit
- 应用范围:
WB IHC
- 靶点:
Uniprot:P19388
- 抗体英文名:
RNA Polymerases I/II/III Subunit ABC1 Rabbit mAb
- 规格:
50ul/100ul
计算分子量:Calculated MW: 25 kDa; Observed MW: 25 kDa
配方:50nM Tris-Glycine(pH 7.4), 0.15M NaCl, 40% Glycerol, 0.01% Sodium azide and 0.05% BSA
应用详情:WB: 1/2000; IHC: 1/20;
图片:

Western blot detection of POLR2E in K562,C6,3T3,Hela cell lysates using POLR2E Rabbit mAb(1:1000 diluted).Predicted band size:25kDa.Observed band size:25kDa.
,
Immunohistochemistry of POLR2E in paraffin-embedded Human breast cancer tissue using POLR2E Rabbit mAb at dilution 1/20
风险提示:丁香通仅作为第三方平台,为商家信息发布提供平台空间。用户咨询产品时请注意保护个人信息及财产安全,合理判断,谨慎选购商品,商家和用户对交易行为负责。对于医疗器械类产品,请先查证核实企业经营资质和医疗器械产品注册证情况。
文献和实验祝贺〖雅裕睿安〗成为Signalway Antibody(SAB)独家
antibody unconjugated; 货号21337,产品描述:GAPDH Antibody;规格 50 ul / 100 ul; 货号3052,产品描述:Rabbit anti-Human IgG secondary antibody HRP conjugated; 货号300904050,产品描述:One-Hour Western kit,10 ml / bottle x 3;
法所替代。利用微球菌核酸酶的切割特性(在染色质核小体之间的 DNA 更容易被切开),可以快速温和地将染色质 DNA 切断,且最大限度地保持了细胞原有染色质结构以及目的蛋白与 DNA 的结合状态,使 ChIP 的准确性和结果可信度大大提高。CST 推出的 SimpleChIP® 酶解法试剂盒,含有标准 ChIP 流程所需的整套试剂、ChIP 级蛋白质 G 微珠、阳性对照抗体(Histone H3(D2B12) XP® Rabbit mAb (ChIP Formulated) #4620)、阴性对照抗体、DNA
【资源】全面归类网址:毕赤酵母表达各种来源蛋白(细菌,真菌,植物,人类等)
allergen Bos d2S, mg amounts, native[160]Mammalian α2,6-sialyltransferaseI and S, active401Mouse ABC transportersI, active513Mouse activin type II receptorS, 5 mg/L, active395Mouse single chain antibody Fv fragments (sFv)S, 250 mg/L, α-MF, PHO1[169, 365
技术资料暂无技术资料 索取技术资料






![PQBP1 Antibody[SAB399]](https://img1.dxycdn.com/p/s14/2025/0922/498/0460884283108299691.jpg!wh200)
![Zfp541 Polyclonal Antibody[29324]](https://img1.dxycdn.com/p/s14/2025/0923/305/2150219664296040791.jpg!wh200)
![NDUFA10 Antibody[36635]](https://img1.dxycdn.com/p/s14/2025/0922/359/6146153295428599691.jpg!wh200)
